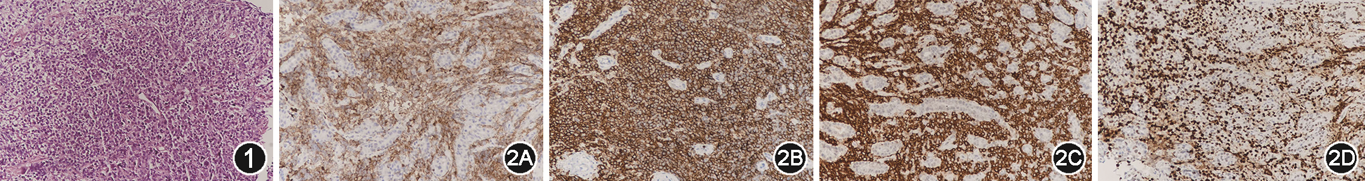

9岁8月龄患儿因“腹痛3个月,胸痛伴面色苍白1 d”入院,临床表现为反复腹痛,胸痛伴面色苍白。胃镜示胃溃疡(性质待定),胃窦黏膜病理考虑非霍奇金淋巴瘤。胃窦免疫组织化学符合弥漫性大B细胞淋巴瘤,生发中心B细胞型。经化疗和抗幽门螺杆菌等治疗,患儿腹痛,贫血症状明显缓解。
版权归中华医学会所有。
未经授权,不得转载、摘编本刊文章,不得使用本刊的版式设计。
除非特别声明,本刊刊出的所有文章不代表中华医学会和本刊编委会的观点。
患儿 男,9岁8月龄,因“腹痛3个月,胸痛伴面色苍白1 d”于2021年11月就诊于江西省儿童医院。患儿3个月前出现阵发性腹痛,无呕吐和呕血,完善相关检查考虑幽门螺杆菌(Helicobacter pylori,HP)感染,给予抗Hp治疗(方案不详),腹痛缓解但易反复。入院前1 d患儿出现胸痛,伴面色苍白,无呕吐、发热,血常规示白细胞计数19.14×109/L,血红蛋白65 g/L,血小板计数494×109/L。病程中有排黑便史。既往无肝脏病史。家族史、出生史无异常。
入院查体:体温 36.5 ℃,脉搏 92 次/min,呼吸 30 次/min,血压 115/81 mmHg(1 mmHg=0.133 kPa),精神差,浅表淋巴结未触及肿大,呼吸稍促,贫血面容,口唇苍白,心肺未见异常,腹平软,剑突下有压痛,无反跳痛,未触及包块,肝肋下2 cm,质软,脾脏肋下未及,无压痛,肠鸣音正常。
实验室检查(括号内为参考值范围):血常规示白细胞计数17.6×109/L(4.6×109~11.9×109/L),中性粒细胞比例0.770(0.220~0.570),中性粒细胞计数13.6×109/L(1.7×109~7.4×109/L),淋巴细胞比例0.173(0.220~0.570),淋巴细胞计数 3.0×109/L(1.7×109~4.7×109/L),红细胞计数2.4×1012/L(4.2×1012~5.7 ×1012/L),血红蛋白60 g/L(121~158 g/L),血小板计数571×109/L(177×109~446×109/L)。肝功能示总蛋白47.6 g/L(65~84 g/L),白蛋白26.0 g/L(39~54 g/L),乳酸脱氢酶 260 U/L(100~240 U/L),C反应蛋白17.12 mg/L(0~3.36 mg/L)。铁蛋白7.6 ng/L(14~142 ng/L),铁 5.1 μmol/L(13~32 μmol/L)。EB病毒核心抗原IgG抗体及衣壳抗原IgG抗体阳性,EB病毒衣壳抗原IgM 阴性。乙肝、丙肝、淋巴细胞亚群、巨细胞病毒、肾功能、凝血功能、粪常规等未见异常。血清Hp分型及抗体均阳性。腹部B超示胃壁明显增厚,肝肋下27 mm,腹腔少量积液。腹部CT示左侧胸膜增厚,胃窦部胃壁不均匀增厚,腹腔积液。骨髓细胞常规示增生性贫血骨髓象。胃镜下食管未见明显异常;胃底黏膜稍充血水肿,可见大量食糜;胃体和胃角可见一巨大不规则溃疡,底高低不平,覆盖污秽物和少许食糜,周围黏膜呈结节样改变,质脆,活检弹性差;胃窦黏膜稍充血水肿;幽门呈圆形,开放状态;十二指肠球部及降部黏膜光滑,形态正常。胃镜诊断:胃溃疡(性质待定)。胃窦黏膜组织病理可见中等偏大异型淋巴样细胞弥漫分布、少量白细胞(图1);考虑非霍奇金淋巴瘤;Hp阳性。免疫组织化学示CD3、CD5、CD7、CD43、Ki-67部分阳性;CD10、CD20、CD79a、Bcl-2、Bcl-6、Mum-1、Pax-5、c-myc、CKpan腺体均阳性;TdT、MPO、EBER、ALK均阴性。符合(胃窦)弥漫性大B细胞淋巴瘤,生发中心B细胞型(germinal centerers B-cell,GCB型)(图2A~2D)。

治疗及随访:入院后予抗Hp(奥美拉唑、克拉霉素、阿莫西林)、营养补液、输血等治疗;结合胃镜和病理组织学检查结果,诊断为原发性胃弥漫性大B细胞淋巴瘤(primary gastric diffuse large B-cell lymphoma,PG-DLBCL)(Ⅲ期)。随后监护人签字出院去外院继续就诊,采用2015年中国抗癌协会儿科专业委员会制定的中国儿童成熟B细胞非霍奇金淋巴瘤(Chinese Children Cancer Group-B cell lymphoma-2015,CCCG-BNHL-2015)诊疗方案化疗;经治疗后患儿无腹痛,贫血症状明显缓解,目前仍在随访中。
原发性胃恶性淋巴瘤(primary gastric malignant lymphoma,PGML)是最常见的来源于结外淋巴组织的非霍奇金淋巴瘤,多发生于成年男性,在儿童人群中发病罕见。Kurucu等[1]对1972至2019年文献报道的1 696例非霍奇金淋巴瘤(non-Hodgkin lymphoma,NHL)进行了回顾性分析,发现16例为PGML,中位年龄10岁,占所有NHL病例的0.94%。PGML常见的组织学亚型是PG-DLBCL和黏膜相关淋巴组织(mucosa-associated lymphoid tissue,MALT)淋巴瘤。MALT淋巴瘤是低级别病变,而PG-DLBCL是高级别病变,预后相对较差,复发率高。Hp在胃MALT淋巴瘤发病机制中的重要作用,也指出其可能参与PG-DLBCL的发生、发展[2]。
PGML临床表现缺乏特异性,根据病变部位不同,症状有所差异。大多数患者主要表现为腹痛,其他常见症状包括腹胀、恶心呕吐、纳差、黑便、贫血、消瘦及发热等,少数以消化道出血、穿孔、肠梗阻等急腹症为首发表现。本例患儿以腹痛、重度贫血为主要症状,与消化性溃疡和胃肠道肿瘤等表现相似,故无法根据临床症状进行鉴别诊断。PGML起源于胃黏膜下层,浸润程度较深。因此,即使经验丰富的临床医师,根据内镜下病变表现诊断PGML的准确率也不是很高[3]。PGML在内镜下表现病变形态各异,暂无统一的形态学描述标准。大多数NHL结外好发部位主要分布于胃,尤以胃窦发生率高。PGML内镜下病变可表现为:溃疡型(巨大溃疡、不规则溃疡和火山样溃疡),肿块型(息肉型和蕈伞型),结节型和黏膜隆起型等。内镜下表现大部分病变以溃疡型为主,尤其是巨大溃疡(直径>2 cm)、不规则溃疡(多发浅表地图样或树枝分支状)以及火山样溃疡对早期诊断有重要的提示作用。虽然卡波西肉瘤或肺恶性肿瘤转移到胃,内镜下病变表现也可能出现火山样溃疡,但通过原发病及影像学检查可以鉴别诊断。儿童胃癌发病率罕见,占所有胃肠道恶性肿瘤的0.05%,内镜下表现为病变处黏膜质脆、易出血,伴有黏膜浸润和溃疡形成,与PGML内镜下表现鉴别存在一定的困难,但生化指标如乳酸脱氢酶对于PGML的诊断及预后均有提示作用[4]。本例患儿乳酸脱氢酶升高,可在一定程度上提示PGML。儿童良性胃溃疡内镜下见黏膜缺失呈椭圆形、圆形、不规则形、线形,底部平坦,边缘整齐,表面附清洁样白苔,或充血黏膜上附着零星白苔,似霜斑,称“霜斑样溃疡”;病变以单发为主,大多数溃疡小(<2 cm)而表浅,增生隆起灶少见,好发部位于胃窦或胃角[5]。本例患儿内镜下可见胃体和胃角可见一巨大不规则溃疡,底高低不平,覆盖污秽物和少许食糜,周围黏膜呈结节样改变,质脆,活检弹性差,提示内镜下病变既表现为溃疡型也表现出结节型病变。与上述儿童良性胃溃疡的内镜特点有所差异。PGML内镜下病变表现为多灶性病变较孤立性病变要多,但本病例内镜下病变表现为一巨大不规则溃疡,属于孤立性病变。
Hp与MALT淋巴瘤的相关性已被研究证实,70%以上的MALT淋巴瘤患者在清除Hp后病情得到缓解[6]。研究表明对于PG-DLBCL根除Hp可使部分患者达到完全缓解,但目前尚未将根除Hp纳入其治疗指南[7]。PG-DLBCL的最佳一线治疗仍存在争议,经典的治疗方案是利妥昔单抗联合蒽环类药物治疗6~8周。化疗不仅提高了患者的生存质量,而且降低了手术并发症,目前不主张手术治疗,手术仅用于有手术指征(如穿孔、压迫、梗阻等)和内镜活检有禁忌证的患者。本例患儿在单纯化疗下取得完全缓解。
所有作者声明无利益冲突





















